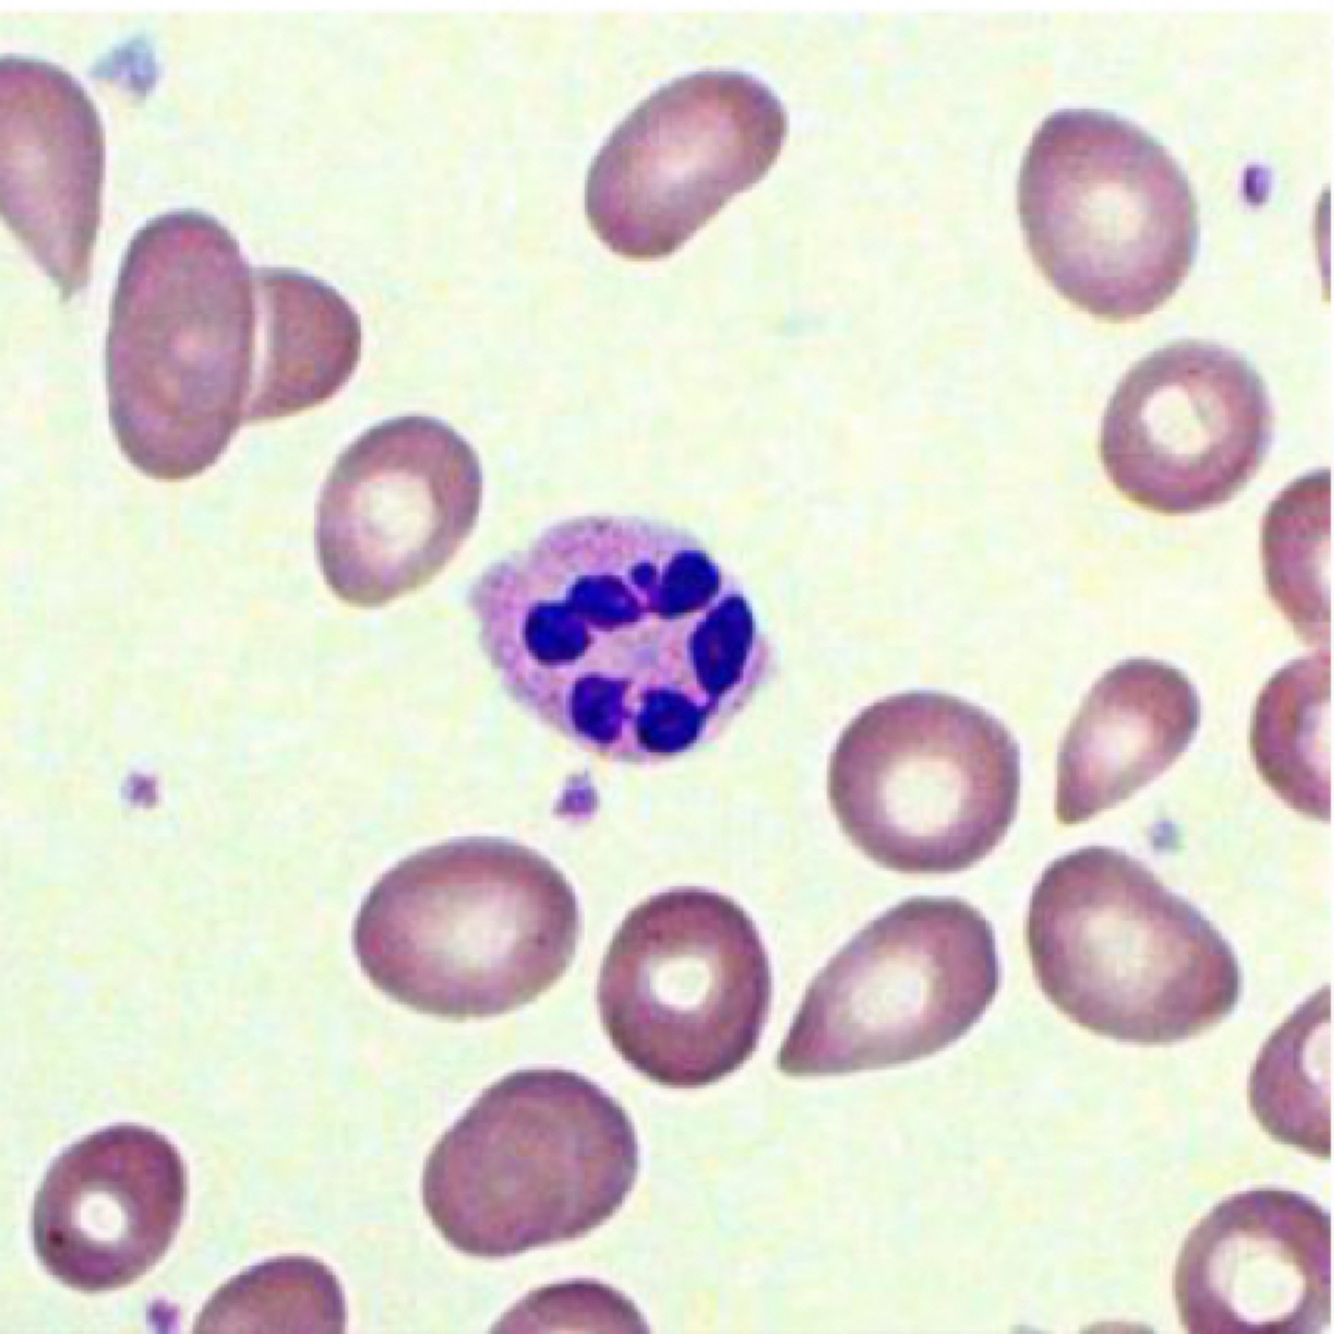

What cell type is this
Neutrophil
Exudate
Fluid released by an organism through pores or wound
Transudate
Fluid accumulation but low/no protein and no cells. Often due to alterations in pressure rather than inflammation.
Effusion
Fluid moving out of blood vessel into the extracellular space
Non-specific term
What are the five categories of effusion?
-Serous
-Catarrhal
-Fibrinous
-Suppurative or Purulent
-Haemorrhagic
What are the features of serous exudate?
Hallmark of early inflammation*
Accumulation of fluid with a low [plasma protein] and no to low numbers of leukocytes
Histology: hyperaemia (vessels filled with blood), increased clear space between tissues and dilated lymphatics

Gross morphology of serous effusion?
Clear fluid exudation, swelling, vesicles, redness.
Examples of serous exudate?
Thermal injury (burn)
Allergies (type I hypersensitivity)
Catarrhal exudate features
Accumulation of a thick gelatinous fluid material containing abundant mucus and mucin from a mucous membrane
-occurs when there is stimulation of mucous production (GIT and respiratory tract)

Catarrhal exudate gross morphology:
Clear to slightly opaque
Thick fluid
-can sometimes have neutrophils depending on severity
Catarrhal exudate- examples
Chronic allergies, autoimmune diseases, infections in regions with lots of mucin producing cells (colon)
Fibrinous inflammation and exudate
- accumulation of fluid with a high concentration of plasma protein and no to low numbers of leukocytes

Fibrinous exudate gross morphology
Affected tissues are red (active hyperaemia) and covered with a thick, stringy, elastic, white-gray to yellow exudate that can be removed from the surface of the tissue.
What is an example where you would see Fibrinous exudate?
Suggestive of more severe endothelial cell injury that allows leakage of large molecular weight proteins such as fibrinogen into the ECF- often caused by microbial infections
Intravascular vs. Extravascular Fibrinous inflammation

Suppurative/purulent exudate features
Accumulation of fluid with a high concentration of plasma protein and high numbers of leukocytes, predominately neutrophils

Gross morphology of purulent exudate
Surfaces and/or connective tissues of the affected organs are hyperemic and covered by or contain, respectively and thick white-grey to yellow exudate (pus)
Ex. Commonly caused by bacterial infection, Suppurative mastitis
When is Suppurative exudate classified as an acute inflammatory process?
If the yellow, creamy fluid is predominately composed of neutrophils and therefore this is classified as an acute inflammatory process
Give a morphological diagnosis

Mammary gland; severe, diffuse, acute to subacute suppurative mastitis.
What is the function of exudation of neutrophils?
- exudation of neutrophils is designed to dilute or wall off an insult
- neutrophils contain a range of substances such as reactive oxygen septics and proteolytic enzymes like myeloperozidase
-these are antimicrobial agents designed to kill bacteria but when released into the tissues they are cytotoxic and can cause significant injury to the resident cell population contributing to tissue damage and necrosis
Haemorrhagic exudates features
-accumulation of fluid containing a lot of erythrocytes
Hemorrhagic exudates gross morphology
Tissues have large areas of red discolouration and fluid is opaque and red/brown


